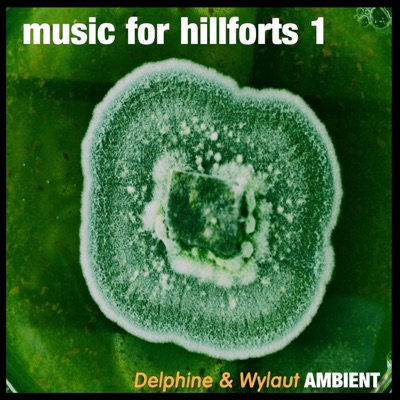
Music For Hillforts 1

Artist on iTunes
Delphine & Wylaut
Worldwide
Popular
#
Title
Actions
Time
1
![e.e & i (A Musical Journey Into the Poems of e.e cummings) [feat. Maggie Nicols & Paul Uden]](https://is1-ssl.mzstatic.com/image/thumb/Music116/v4/5e/39/48/5e394883-ee99-3bcc-08f3-0af65bdb477e/artwork.jpg/400x400bb.jpg)
Seeker of Truth (feat. Maggie Nicols & Paul Uden)
5
![e.e & i (A Musical Journey Into the Poems of e.e cummings) [feat. Maggie Nicols & Paul Uden]](https://is1-ssl.mzstatic.com/image/thumb/Music116/v4/5e/39/48/5e394883-ee99-3bcc-08f3-0af65bdb477e/artwork.jpg/400x400bb.jpg)
Little Tree (feat. Maggie Nicols & Paul Uden)
6
![e.e & i (A Musical Journey Into the Poems of e.e cummings) [feat. Maggie Nicols & Paul Uden]](https://is1-ssl.mzstatic.com/image/thumb/Music116/v4/5e/39/48/5e394883-ee99-3bcc-08f3-0af65bdb477e/artwork.jpg/400x400bb.jpg)
Air (feat. Maggie Nicols & Paul Uden)
10
![e.e & i (A Musical Journey Into the Poems of e.e cummings) [feat. Maggie Nicols & Paul Uden]](https://is1-ssl.mzstatic.com/image/thumb/Music116/v4/5e/39/48/5e394883-ee99-3bcc-08f3-0af65bdb477e/artwork.jpg/400x400bb.jpg)
Sitting In a Tree (feat. Maggie Nicols & Paul Uden)
12
![e.e & i (A Musical Journey Into the Poems of e.e cummings) [feat. Maggie Nicols & Paul Uden]](https://is1-ssl.mzstatic.com/image/thumb/Music116/v4/5e/39/48/5e394883-ee99-3bcc-08f3-0af65bdb477e/artwork.jpg/400x400bb.jpg)
O Sweet Spontaneous Earth (feat. Maggie Nicols & Paul Uden)
14
![e.e & i (A Musical Journey Into the Poems of e.e cummings) [feat. Maggie Nicols & Paul Uden]](https://is1-ssl.mzstatic.com/image/thumb/Music116/v4/5e/39/48/5e394883-ee99-3bcc-08f3-0af65bdb477e/artwork.jpg/400x400bb.jpg)
As Freedom Is a Breakfast Food (feat. Maggie Nicols, Paul Uden & John Bentley) [Radio Edit]